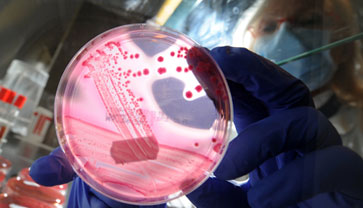

- Главная
- Тематический дневник
- Безопасность и закон
E.coli 0104: охота продолжается
Роспотребнадзор постепенно ослабляет режим овощного эмбарго. Сегодня снимается запрет на поставки агропродукции из Польши. «После рассмотрения представленных документов Роспотребнадзор принял решение о возобновлении импорта овощей из Польши», – отметили в пресс-службе этого ведомства.
Ранее Роспотребнадзор снял запрет на ввоз овощей из Чехии и Греции. Таким образом, на прилавки российских магазинов теперь поступают овощи из семи стран ЕС, в том числе из Испании, Нидерландов, Бельгии, Дании. Ожидают рассмотрения документы из стран Балтии, а также Словакии и Словении.
Шлагбаум перед зеленой продукцией из стран Европы поднялся после того, как 22 июня российские власти и представители Евросоюза подписали в Москве документ, позволяющий возобновить импорт европейских овощей в Россию. В соответствии с достигнутым соглашением, поставки овощей из стран Евросоюза должны сопровождаться особыми сертификатами, подтверждающими происхождение продукта и отсутствие в нем бактерии E.coli 0104:H4, которая вызвала эпидемию опасной кишечной инфекции.
Эмбарго на поставки овощей из ЕС в РФ было введено 2 июня после того, как по причине острой кишечной инфекции, вызванной этой бактерией, в Германии умерло несколько человек. У всех заболевших отмечалось сильное внутреннее кровотечение, а также тяжелое поражение почек.
Первоначально было объявлено, что виноваты огурцы, поставлявшиеся из Испании, но вскоре испанские фермеры доказали, что их продукция не была заражена. Затем подозрение пало на проростки сои, которые производились на одной из германских ферм, но и здесь ничего доказать не удалось. Последняя версия – опасный штамм кишечной палочки попал в Европу вместе с партией зерна из Египта.
Тот факт, что европейским врачам так и не удалось установить точное происхождение опасной бактерии, заставлял российские санитарные власти поддерживать запрет на поставки овощей.
В Европе по-прежнему выясняют свойства опасной бактерии и путь, которым она проникла на континент. В городе Геттинген восемь человек заразились на вечеринке, и газета «Ганноверише альгемайне цайтунг» пишет, что власти земли Гессен изучают возможность передачи заболевания через человека.
Пока происхождение бактерии и пути ее распространения остаются неясными. Куда более понятна ситуация в аграрной сфере, которая понесла большие убытки. Фермеры были вынуждены уничтожить до 80 % урожая из-за резко упавшего потребительского спроса на овощную продукцию. По данным фермерской организации Copa-Cogeca, европейские аграрии теряли примерно 400 млн евро в неделю.
Власти Евросоюза разработали план помощи европейским фермерам, согласно которому им будет направлено 150 млн евро. Однако, как указывают эксперты, эта сумма покроет только часть прямых убытков. Основной же ущерб фермерам приносит резко сократившийся спрос на свежие овощи, в особенности на огурцы, помидоры и салат. Непроданную продукцию им приходится уничтожать, что только увеличивает размер убытков. По данным организации «Фрешфель», спрос на огурцы в ряде регионов исчезал полностью, а продажи помидоров сокращались от 50 до 80 %. Организация считает, что для повышения спроса следовало потратить порядка 55 млн евро на кампанию, разъясняющую безопасность свежих овощей. Пока же еврочиновники предлагают платить фермерам за уничтоженную продукцию до 30 % от средней рыночной стоимости овощей.
ТПП-Информ
При перепечатке материалов ТПП-Информ ссылка на интернет-издание обязательна.








